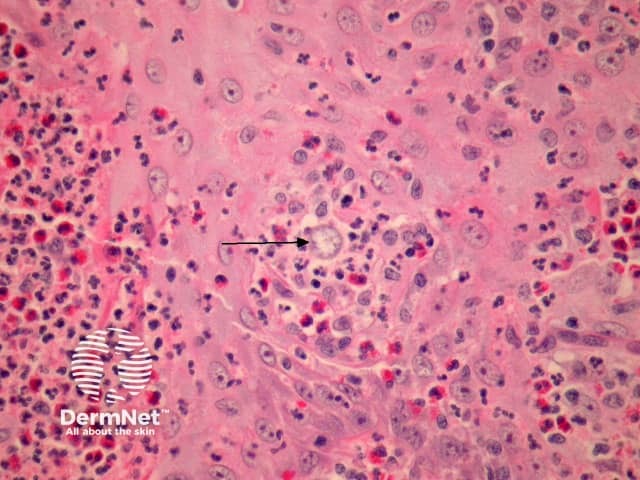
Figure 2

Main menu
Common skin conditions
NEWS
Join DermNet PRO
Read more
Quick links
Infections Diagnosis and testing
Author: Assoc Prof Patrick Emanuel, Dermatopathologist, Auckland, New Zealand, 2013.
Introduction Histology Special stains Differential diagnoses
Coccidioidomycosis immitis is a dimorphic fungus which occurs almost exclusively in residents or visitors to the Southwestern United States. Cutaneous lesions containing the organisms on biopsy may be the presenting sign of disseminated coccidioidomycosis. Dissemination is typically seen in the immunosuppressed.
In coccidioidomycosis, there is massive pseudoepitheliomatous hyperplasia and granulomatous dermal inflammation (figure 1). Often careful searching is required to find the spherules (100 µm) that contain endospores (up to 5 µm) at high power (figures 2, 3, arrow indicates spherules). The surrounding infiltrate is often rich in chronic inflammatory cells, eosinophils, neutrophils and granulomatous inflammation.

Figure 1
Figure 2

Figure 3
Silver stain preparations highlight the coccidioidomycosis organisms. The endospores are PAS positive, but the spherules are negative.
Blastomycosis or paracoccidioidomycosis – Fragmented or immature coccidioidomycosis may closely resemble these other infections. Culture or PCR can be helpful in difficult cases.
Squamous cell carcinoma, halogenoderma, mycobacterial infection – The massive epidermal hyperplasia which often accompanies coccidioidomycosis my cause diagnostic confusion with these other diverse pathologic processes.